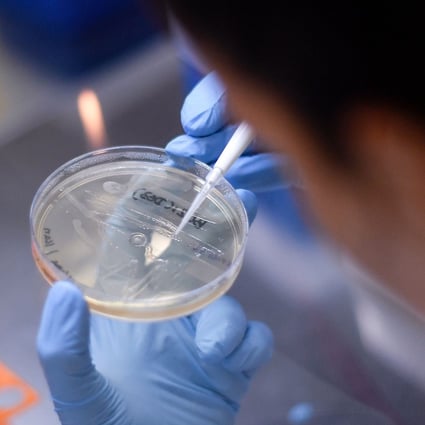

Updates On Novel Corona Virus Covid 19
Updates On Novel Corona Virus Covid 19

 Corona Virus Bird Flu District Nanded Government Of Maharashtra India
Corona Virus Bird Flu District Nanded Government Of Maharashtra India

Coronavirus And Social Distancing How To Have Safe Sex Times Of India
Coronavirus And Social Distancing How To Have Safe Sex Times Of India

 Covid 19 Vaccine Dry Run Explained Here Is Why Coronavirus Vaccine Dry Run Was Critical
Covid 19 Vaccine Dry Run Explained Here Is Why Coronavirus Vaccine Dry Run Was Critical
 Japan Reports Another New Strain Of Coronavirus Zee News
Japan Reports Another New Strain Of Coronavirus Zee News


 Coronavirus Covid 19 Important Questions Corona Virus Explained In Hindi Current Affairs 2020 Youtube
Coronavirus Covid 19 Important Questions Corona Virus Explained In Hindi Current Affairs 2020 Youtube
 Why Some Patients Test Positive Even After Recovering From Covid 19 Times Of India
Why Some Patients Test Positive Even After Recovering From Covid 19 Times Of India
 Mumbai News Latest News With Live Updates And Videos Information About Emergency Services In English Hindi And Marathi
Mumbai News Latest News With Live Updates And Videos Information About Emergency Services In English Hindi And Marathi
 Bangladesh Confirms First Case Of Coronavirus
Bangladesh Confirms First Case Of Coronavirus
 Can Keto Diet Protect You From Coronavirus Times Of India
Can Keto Diet Protect You From Coronavirus Times Of India
 5 Kadam Corona Mukt Jeevan Marathi Youtube
5 Kadam Corona Mukt Jeevan Marathi Youtube
 Coronavirus Disease Covid 19 Dexamethasone
Coronavirus Disease Covid 19 Dexamethasone
 Coronavirus Prevention What Is Your Best Defence Against Covid 19 Times Of India
Coronavirus Prevention What Is Your Best Defence Against Covid 19 Times Of India
 Coronavirus Outbreak How To Protect Yourself Kids Learning Cartoon Dr Panda Tototime Youtube
Coronavirus Outbreak How To Protect Yourself Kids Learning Cartoon Dr Panda Tototime Youtube


 Serum Institute Hopes To Roll Out A Covid 19 Vaccine Is This Realistic Business Standard News
Serum Institute Hopes To Roll Out A Covid 19 Vaccine Is This Realistic Business Standard News



